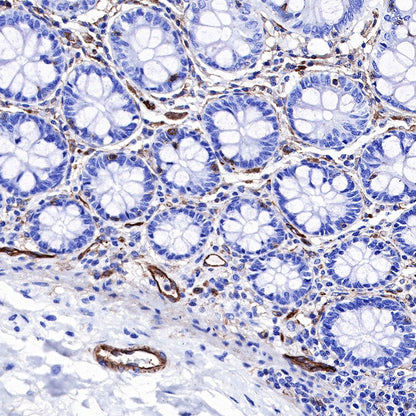
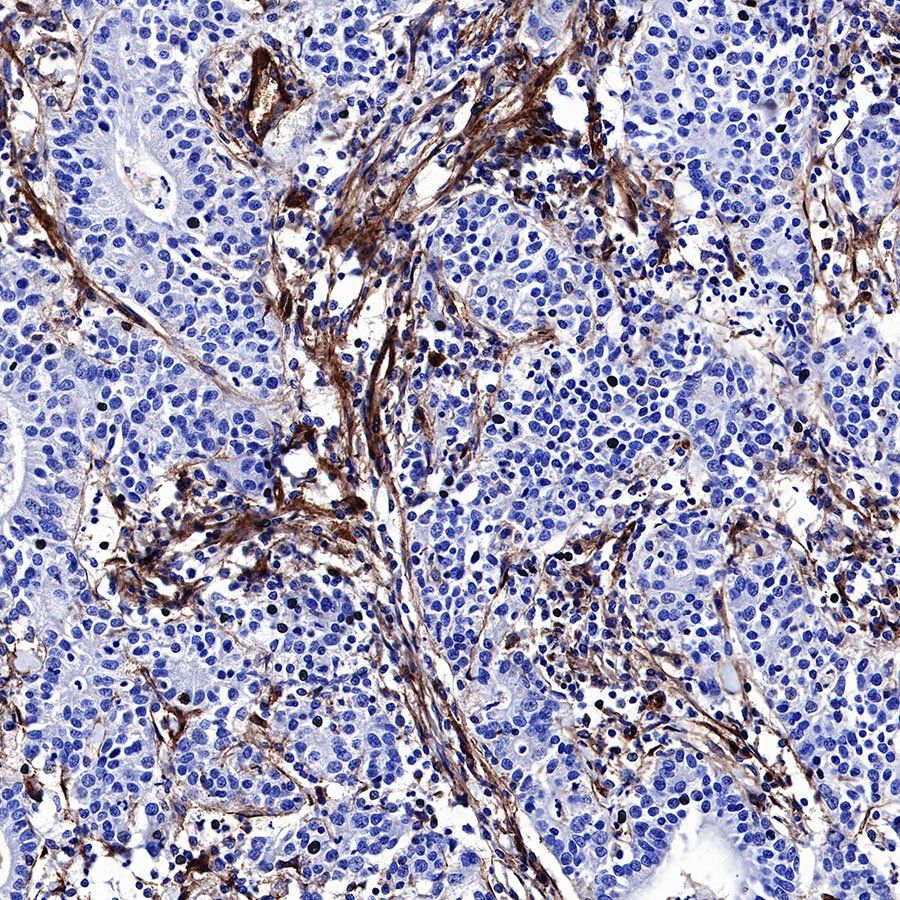

IHC shows positive staining in paraffin-embedded human placenta. Anti-CD39 antibody was used at 1/500 dilution, followed by a HRP Polymer for Mouse & Rabbit IgG (ready to use). Counterstained with hematoxylin. Heat mediated antigen retrieval with Tris/EDTA buffer pH9.0 was performed before commencing with IHC staining protocol.
Product Details
Product Details
Product Specification
Host | Rabbit |
Antigen | CD39 |
Synonyms | Ectonucleoside triphosphate diphosphohydrolase 1, NTPDase 1, Ecto-ATPDase 1, Lymphoid cell activation antigen |
Immunogen | Recombinant Protein |
Location | Membrane |
Accession | P49961 |
Clone Number | SDT-236-20 |
Antibody Type | Rabbit mAb |
Application | IHC-P |
Reactivity | Hu |
Purification | Protein A |
Concentration | 0.5 mg/ml |
Physical Appearance | Liquid |
Storage Buffer | PBS, 40% Glycerol, 0.05% BSA, 0.03% Proclin 300 |
Stability & Storage | 12 months from date of receipt / reconstitution, -20 °C as supplied |
Dilution
application | dilution | species |
IHC-P | 1:500 | null |
Background
CD39 is an ectoenzyme (ecto-nucleotide triphosphate diphosphohydrolase 1, encoded by ENTPD1 gene) belonging to the family of ectonucleotidases which comprises ecto-5'-nucleotidase (NT5E)/CD73, CD38/NADase, NAD glycohydrolases, nucleoside diphosphate kinase, ecto-nucleotide pyrophosphate phosphodiesterases (E-NPPs), ecto nucleoside triphosphate diphosphohydrolases (ENTPDases), and adenylate kinases [PMID: 34360833].
Picture
Picture
Immunohistochemistry


IHC shows positive staining in paraffin-embedded human colon. Anti-CD39 antibody was used at 1/500 dilution, followed by a HRP Polymer for Mouse & Rabbit IgG (ready to use). Counterstained with hematoxylin. Heat mediated antigen retrieval with Tris/EDTA buffer pH9.0 was performed before commencing with IHC staining protocol.

IHC shows positive staining in paraffin-embedded human cardiac muscle. Anti-CD39 antibody was used at 1/500 dilution, followed by a HRP Polymer for Mouse & Rabbit IgG (ready to use). Counterstained with hematoxylin. Heat mediated antigen retrieval with Tris/EDTA buffer pH9.0 was performed before commencing with IHC staining protocol.

IHC shows positive staining in paraffin-embedded human gastric cancer. Anti-CD39 antibody was used at 1/500 dilution, followed by a HRP Polymer for Mouse & Rabbit IgG (ready to use). Counterstained with hematoxylin. Heat mediated antigen retrieval with Tris/EDTA buffer pH9.0 was performed before commencing with IHC staining protocol.

IHC shows positive staining in paraffin-embedded human lung adenocarcinoma. Anti-CD39 antibody was used at 1/500 dilution, followed by a HRP Polymer for Mouse & Rabbit IgG (ready to use). Counterstained with hematoxylin. Heat mediated antigen retrieval with Tris/EDTA buffer pH9.0 was performed before commencing with IHC staining protocol.

IHC shows positive staining in paraffin-embedded human lung squamous carcinoma. Anti-CD39 antibody was used at 1/500 dilution, followed by a HRP Polymer for Mouse & Rabbit IgG (ready to use). Counterstained with hematoxylin. Heat mediated antigen retrieval with Tris/EDTA buffer pH9.0 was performed before commencing with IHC staining protocol.